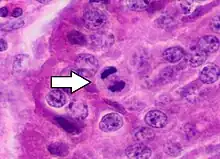

Neuroendocrine tumor
| Neuroendocrine tumor | |
|---|---|
 | |
| Micrograph of a neuroendocrine tumor. H&E stain. | |
| Specialty | Endocrine oncology |
Neuroendocrine tumors (NETs) are neoplasms that arise from cells of the endocrine (hormonal) and nervous systems. They most commonly occur in the intestine, where they are often called carcinoid tumors, but they are also found in the pancreas, lung, and the rest of the body.
Although there are many kinds of NETs, they are treated as a group of tissue because the cells of these neoplasms share common features, including a similar histological appearance, having special secretory granules, and often producing biogenic amines and polypeptide hormones.[1]
The term "neuro" refers to the dense core granules (DCGs), similar to the DCGs in the serotonergic neurons storing monoamines. The term "endocrine" refers to the synthesis and secretion of these monoamines. The neuroendocrine system includes endocrine glands such as the pituitary, the parathyroids and the neuroendocrine adrenals, as well as endocrine islet tissue embedded within glandular tissue such as in the pancreas, and scattered cells in the exocrine parenchyma. The latter is known as the diffuse endocrine system.[2][3]
Classification
WHO
The World Health Organization (WHO) classification scheme places neuroendocrine tumors into three main categories, which emphasize the tumor grade rather than the anatomical origin:[4][5]
- well-differentiated neuroendocrine tumors, further subdivided into tumors with benign and those with uncertain behavior
- well-differentiated (low grade) neuroendocrine carcinomas with low-grade malignant behavior
- poorly differentiated (high grade) neuroendocrine carcinomas, which are the large cell neuroendocrine and small cell carcinomas.
Additionally, the WHO scheme recognizes mixed tumors with both neuroendocrine and epithelial carcinoma features, such as goblet cell cancer, a rare gastrointestinal tract tumor.[6]
Placing a given tumor into one of these categories depends on well-defined histological features: size, lymphovascular invasion, mitotic count, Ki-67 labelling index, invasion of adjacent organs, presence of metastases and whether they produce hormones.[4][5]
The WHO grading from 2022 endorses a three-tiered grading system for most NETs, in particular NETs of the gastrointestinal or pancreaticobiliary tract, as well as NETs of the upper aerodigestive tract and the salivary glands. The grading system is based on proliferation assessed by mitotic rate and Ki-67 index and stratifies NETs into grade 1 (G1, low-grade), grade 2 (G2, intermediate-grade) and grade 3 (G3, high-grade). Tumor necrosis, although recognized as a factor associated with a potentially worse prognosis, is not included in the grading of NETs of the gastrointestinal or pancreaticobiliary tract. However, the absence or presence of tumor necrosis is a component of the grading of NETs of many other origins, such as the upper aerodigestive tract, the lung and the thymus.[7]
Neuroendocrine carcinomas are poorly differentiated high-grade neuroendocrine neoplasms and a designation of tumor grade is therefore redundant.[7] Lung and thymic neuroendocrine neoplasms are classified in a similar manner, including typical and atypical carcinoids, small cell and large cell neuroendocrine carincomas.[7]
Furthermore, the 2022 WHO classification introduces a two-tiered grading system for medullary thyroid carcinomas based on mitotic count, Ki-67 index and the absence or presence of tumor necrosis. Here, it may be noted that different cut-offs than with tumors of gastrointestinal, aerodigestive and lung origin are applied.[7]
Anatomic distribution
Traditionally, neuroendocrine tumors have been classified by their anatomic site of origin. NETs can arise in many different areas of the body, and are most often located in the intestine, pancreas or the lungs. The various kinds of cells that can give rise to NETs are present in endocrine glands and are also diffusely distributed throughout the body, most commonly Kulchitsky cells or similar enterochromaffin-like cells, that are relatively more common in the gastrointestinal and pulmonary systems.[8]
NETs include certain tumors of the gastrointestinal tract and of the pancreatic islet cells,[1] certain thymus and lung tumors, and medullary carcinoma of the parafollicular cells of the thyroid.[1] Tumors with similar cellular characteristics in the pituitary, parathyroid, and adrenomedullary glands are sometimes included[9] or excluded.[1]
Within the broad category of neuroendocrine tumors there are many different tumor types,[10] representing only a small proportion of the tumors or cancers in most of these tissues:
- Pituitary gland: Neuroendocrine tumor of the anterior pituitary
- Thyroid gland: Neuroendocrine thyroid tumors, particularly medullary carcinoma
- Parathyroid tumors
- Thymus and mediastinal carcinoid tumors[11][12]
- Pulmonary neuroendocrine tumors[13][14]
- bronchus[12]
- pulmonary carcinoid tumors: typical carcinoid (TC; low-grade); atypical carcinoid (AC; intermediate-grade)
- small-cell lung cancer (SCLC)
- large cell neuroendocrine carcinoma of the lung (LCNEC)[15]
- Extrapulmonary small cell carcinomas (ESCC or EPSCC)
- Gastroenteropancreatic neuroendocrine tumors (GEP-NET)[16][17]
- Foregut GEP-NET (foregut tumors can conceptually encompasses not only NETs of the stomach and proximal duodenum, but also the pancreas, and even thymus, lung and bronchus)
- Pancreatic endocrine tumors (if considered separately from foregut GEP-NET)[18]
- Midgut GEP-NET (from distal half of 2nd part of the duodenum to the proximal two-thirds of the transverse colon)
- appendix,[19] including well differentiated NETs (benign); well differentiated NETs (uncertain malignant potential); well differentiated neuroendocrine carcinoma (with low malignant potential); mixed exocrine-neuroendocrine carcinoma (goblet cell carcinoma, also called adenocarcinoid and mucous adenocarcinoid)
- Hindgut GEP-NET[20][21]
- Foregut GEP-NET (foregut tumors can conceptually encompasses not only NETs of the stomach and proximal duodenum, but also the pancreas, and even thymus, lung and bronchus)
- Liver[22][23][24] and gallbladder[25]
- Adrenal tumors, particularly adrenomedullary tumors
- Pheochromocytoma
- Peripheral nervous system tumors, such as:
- Breast[26]
- Genitourinary tract
- Merkel cell carcinoma of skin (trabecular cancer)
- Inherited conditions:[32]
Grading
Neuroendocrine lesions are graded histologically according to markers of cellular proliferation, rather than cellular polymorphism. The following grading scheme is currently recommended for all gastroenteropancreatic neuroendocrine neoplasms by the World Health Organization:[38]
| G | Mitotic count (per 10 HPF) | Ki-67 index (%) |
|---|---|---|
| GX | Grade cannot be assessed | |
| G1 | < 2 | < 3% |
| G2 | 2 to 20 | 3–20% |
| G3 | > 20 | > 20% |
If mitotic count and Ki-67 are discordant, the figure which gives the highest grade is used.
G1 and G2 neuroendocrine neoplasms are called neuroendocrine tumors (NETs) – formerly called carcinoid tumours. G3 neoplasms are called neuroendocrine carcinomas (NECs).
It has been proposed that the current G3 category be further separated into histologically well-differentiated and poorly-differentiated neoplasms to better reflect prognosis.[39]
Staging

Currently there is no one staging system for all neuroendocrine neoplasms. Well-differentiated lesions generally have their own staging system based on anatomical location, whereas poorly differentiated and mixed lesions are staged as carcinomas of that location. For example, gastric NEC and mixed adenoneuroendocrine cancers are staged as primary carcinoma of the stomach.[40]
TNM staging of gastroenteropancreatic Grade 1 and Grade 2 neuroendocrine tumors are as follows:
| Primary Tumor (T) | |
|---|---|
| T Category | Tumor Criteria |
| TX | Primary tumour cannot be assessed |
| T0 | No evidence of primary tumour |
| T1 | Invades the lamina propria or submucosa, and less than or equal to 1 cm in size |
| T2 | Invades the muscularis propria, or greater than 1 cm in size |
| T3 | Invades through the muscularis propria into subserosal tissue without penetration of overlying serosa |
| T4 | Invades visceral peritoneum (serosal) or other organs or adjacent structures |
| Regional Lymph Node (N) | |
| N Category | N Criteria |
| NX | Regional lymph nodes cannot be assessed |
| N0 | No regional lymph node metastasis |
| N1 | Regional lymph node metastasis |
| Distant Metastasis (M) | |
| M Category | M Criteria |
| M0 | No distant metastasis |
| M1 | Distant metastasis |
| M1a | Metastasis confined to liver |
| M1b | Metastasis in at least one extra-hepatic site |
| M1c | Both hepatic and extra-hepatic metastases |
| AJCC Prognostic Stage Groups | |
| Stage | Criteria |
| I | T1, N0, M0 |
| II | T2 or T3, N0, M0 |
| III | Any T, N1, M0; T4, N0, M0 |
| IV | Any T, any N, M1 |
| Primary Tumor (T) | |
|---|---|
| T Category | Tumor Criteria |
| TX | Primary tumour cannot be assessed |
| T1 | Invades the mucosa or submucosa only, and less than or equal to 1 cm in size (duodenal tumors) Confined within the sphincter of Oddi, and less than or equal to 1 cm in size (ampullary tumors) |
| T2 | Invades the muscularis propria, or is > 1 cm (duodenal) Invades through sphincter into duodenal submucosa or muscularis propria, or is > 1 cm (ampullary) |
| T3 | Invades the pancreas or peripancreatic adipose tissue |
| T4 | Invades visceral peritoneum (serosal) or other organs |
| Regional Lymph Node (N) | |
| N Category | N Criteria |
| NX | Regional lymph nodes cannot be assessed |
| N0 | No regional lymph node metastasis |
| N1 | Regional lymph node metastasis |
| Distant Metastasis (M) | |
| M Category | M Criteria |
| M0 | No distant metastasis |
| M1 | Distant metastasis |
| M1a | Metastasis confined to liver |
| M1b | Metastasis in at least one extra-hepatic site |
| M1c | Both hepatic and extra-hepatic metastases |
| AJCC Prognostic Stage Groups | |
| Stage | Criteria |
| I | T1, N0, M0 |
| II | T2 or T3, N0, M0 |
| III | T4, N0, M0; Any T, N1, M0 |
| IV | Any T, any N, M1 |
| Primary Tumor (T) | |
|---|---|
| T Category | Tumor Criteria |
| TX | Primary tumour cannot be assessed |
| T0 | No evidence of primary tumour |
| T1 | Invades the lamina propria or submucosa, and less than or equal to 1 cm in size |
| T2 | Invades the muscularis propria, or greater than 1 cm in size |
| T3 | Invades through the muscularis propria into subserosal tissue without penetration of overlying serosa |
| T4 | Invades visceral peritoneum (serosal) or other organs or adjacent structures |
| Regional Lymph Node (N) | |
| N Category | N Criteria |
| NX | Regional lymph nodes cannot be assessed |
| N0 | No regional lymph node metastasis |
| N1 | Regional lymph node metastasis less than 12 nodes |
| N2 | Large mesenteric masses (> 2 cm) and / or extensive nodal deposits (12 or greater), especially those that encase the superior mesenteric vessels |
| Distant Metastasis (M) | |
| M Category | M Criteria |
| M0 | No distant metastasis |
| M1 | Distant metastasis |
| M1a | Metastasis confined to liver |
| M1b | Metastasis in at least one extra-hepatic site |
| M1c | Both hepatic and extra-hepatic metastases |
| AJCC Prognostic Stage Groups | |
| Stage | Criteria |
| I | T1, N0, M0 |
| II | T2 or T3, N0, M0 |
| III | Any T, N1 or N2, M0; T4, N0, M0; |
| IV | Any T, any N, M1 |
| Primary Tumor (T) | |
|---|---|
| T Category | Tumor Criteria |
| TX | Primary tumour cannot be assessed |
| T0 | No evidence of primary tumour |
| T1 | 2 cm or less in greatest dimension |
| T2 | Tumor more than 2 cm but less than or equal to 4 cm |
| T3 | Tumor more than 4 cm or with subserosal invasion or involvement of the mesoappendix |
| T4 | Perforates the peritoneum or directly invades other organs or structures (excluding direct mural extension to adjacent subserosa of adjacent bowel) |
| Regional Lymph Node (N) | |
| N Category | N Criteria |
| NX | Regional lymph nodes cannot be assessed |
| N0 | No regional lymph node metastasis |
| N1 | Regional lymph node metastasis |
| Distant Metastasis (M) | |
| M Category | M Criteria |
| M0 | No distant metastasis |
| M1 | Distant metastasis |
| M1a | Metastasis confined to liver |
| M1b | Metastasis in at least one extra-hepatic site |
| M1c | Both hepatic and extra-hepatic metastases |
| AJCC Prognostic Stage Groups | |
| Stage | Criteria |
| I | T1, N0, M0 |
| II | T2 or T3, N0, M0 |
| III | Any T, N1, M0; T4, N1, M0 |
| IV | Any T, any N, M1 |
| Primary Tumor (T) | |
|---|---|
| T Category | Tumor Criteria |
| TX | Primary tumour cannot be assessed |
| T0 | No evidence of primary tumour |
| T1 | Invades the lamina propria or submucosa, and less than or equal to 2 cm |
| T1a | Less than 1 cm in greatest dimension |
| T1b | 1–2 cm in greatest dimension |
| T2 | Invades the muscularis propria, or greater than 2 cm in size with invasion of the lamina propria or submucosa |
| T3 | Invades through the muscularis propria into subserosal tissue without penetration of overlying serosa |
| T4 | Invades visceral peritoneum (serosal) or other organs or adjacent structures |
| Regional Lymph Node (N) | |
| N Category | N Criteria |
| NX | Regional lymph nodes cannot be assessed |
| N0 | No regional lymph node metastasis |
| N1 | Regional lymph node metastasis |
| Distant Metastasis (M) | |
| M Category | M Criteria |
| M0 | No distant metastasis |
| M1 | Distant metastasis |
| M1a | Metastasis confined to liver |
| M1b | Metastasis in at least one extra-hepatic site |
| M1c | Both hepatic and extra-hepatic metastases |
| AJCC Prognostic Stage Groups | |
| Stage | Criteria |
| I | T1, N0, M0 |
| IIA | T2, N0, M0 |
| IIB | T3, N0, M0 |
| IIIA | T4, N0, M0 |
| IIIB | Any T, N1, M0 |
| IV | Any T, any N, M1 |
| Primary Tumor (T) | |
|---|---|
| T Category | Tumor Criteria |
| TX | Primary tumour cannot be assessed |
| T1 | Limited to the pancreas, less than or equal to 2 cm in size |
| T2 | Limited to the pancreas, 2–4 cm in size |
| T3 | Limited to the pancreas, > 4 cm; or invading the duodenum or bile duct |
| T4 | Invading adjacent organs or the wall of large vessels |
| Regional Lymph Node (N) | |
| N Category | N Criteria |
| NX | Regional lymph nodes cannot be assessed |
| N0 | No regional lymph node involvement |
| N1 | Regional lymph node involvement |
| Distant Metastasis (M) | |
| M Category | M Criteria |
| M0 | No distant metastasis |
| M1 | Distant metastasis |
| M1a | Metastasis confined to liver |
| M1b | Metastasis in at least one extra-hepatic site |
| M1c | Both hepatic and extra-hepatic metastases |
| AJCC Prognostic Stage Groups | |
| Stage | Criteria |
| I | T1, N0, M0 |
| II | T2 or T3, N0, M0 |
| III | Any T, N1, M0; T4, N0, M0 |
| IV | Any T, any N, M1 |
Signs and symptoms
Gastroenteropancreatic
Conceptually, there are two main types of NET within the gastroenteropancreatic neuroendocrine tumors (GEP-NET) category: those which arise from the gastrointestinal (GI) system and those that arise from the pancreas. In usage, the term "carcinoid" has often been applied to both, although sometimes it is restrictively applied to NETs of GI origin (as herein), or alternatively to those tumors which secrete functional hormones or polypeptides associated with clinical symptoms, as discussed.
Carcinoid tumors
Carcinoids most commonly affect the small bowel, particularly the ileum, and are the most common malignancy of the appendix. Many carcinoids are asymptomatic and are discovered only upon surgery for unrelated causes. These coincidental carcinoids are common; one study found that one person in ten has them.[47] Many tumors do not cause symptoms even when they have metastasized.[48] Other tumors even if very small can produce adverse effects by secreting hormones.[49]
Ten per cent (10%)[50] or less of carcinoids, primarily some midgut carcinoids, secrete excessive levels of a range of hormones, most notably serotonin (5-HT) or substance P,[51] causing a constellation of symptoms called carcinoid syndrome:
- flushing
- diarrhea
- asthma or wheezing
- congestive heart failure (CHF)
- abdominal cramping
- peripheral edema
- heart palpitations
A carcinoid crisis with profound flushing, bronchospasm, tachycardia, and widely and rapidly fluctuating blood pressure[1] can occur if large amounts of hormone are acutely secreted,[51] which is occasionally triggered by factors such as diet,[51] alcohol,[51] surgery[1][51] chemotherapy,[51] embolization therapy or radiofrequency ablation.[1]
Chronic exposure to high levels of serotonin causes thickening of the heart valves, particularly the tricuspid and the pulmonic valves, and over a long period can lead to congestive heart failure.[51] However, valve replacement is rarely needed.[52] The excessive outflow of serotonin can cause a depletion of tryptophan leading to niacin deficiency, and thus pellagra,[1] which is associated with dermatitis, dementia, and diarrhea. Many other hormones can be secreted by some of these tumors, most commonly growth hormone that can cause acromegaly, or cortisol, that can cause Cushing's syndrome.[53]
Occasionally, haemorrhage or the effects of tumor bulk are the presenting symptoms. Bowel obstruction can occur, sometimes due to fibrosing effects of NET secretory products[49] with an intense desmoplastic reaction at the tumor site, or of the mesentery.
Pancreatic neuroendocrine tumors
Pancreatic neuroendocrine tumors (PanNETs) are often referred to as "islet cell tumors",[54][55] or "pancreatic endocrine tumors"[4]
The PanNET denomination is in line with current WHO guidelines. Historically, PanNETs have also been referred to by a variety of terms, and are still often called "islet cell tumors" or "pancreatic endocrine tumors".[4] originate within the pancreas. PanNETs are quite distinct from the usual form of pancreatic cancer, adenocarcinoma, which arises in the exocrine pancreas. About 95 percent of pancreatic tumors are adenocarcinoma; only 1 or 2% of clinically significant pancreas neoplasms are GEP-NETs.
Well or intermediately differentiated PanNETs are sometimes called islet cell tumors; neuroendocrine cancer (NEC) (synonymous with islet cell carcinoma) is more aggressive. Up to 60% of PanNETs are nonsecretory or nonfunctional, which either don't secrete, or the quantity or type of products such as pancreatic polypeptide (PPoma), chromogranin A, and neurotensin do not cause a clinical syndrome, although blood levels may be elevated.[32] Functional tumors are often classified by the hormone most strongly secreted by the pancreatic neuroendocrine tumor, as discussed in that main article.
Other
In addition to the two main categories of GEP-NET, there are rarer forms of neuroendocrine tumors that arise anywhere in the body, including within the lung, thymus and parathyroid. Bronchial carcinoid can cause airway obstruction, pneumonia, pleurisy, difficulty with breathing, cough, and hemoptysis, or may be associated with weakness, nausea, weight loss, night sweats, neuralgia, and Cushing's syndrome. Some are asymptomatic.Animal neuroendocrine tumors include neuroendocrine cancer of the liver in dogs, and devil facial tumor disease in Tasmanian devils.[56][57][58]
Familial syndromes
Most pancreatic NETs are sporadic.[54] However, neuroendocrine tumors can be seen in several inherited familial syndromes, including:[32]
- multiple endocrine neoplasia type 1 (MEN1)
- multiple endocrine neoplasia type 2 (MEN2)
- von Hippel-Lindau (VHL) disease[32]
- neurofibromatosis type 1[33]
- tuberous sclerosis[34][35]
- Carney complex[36][37]
Given these associations, recommendations in NET include family history evaluation, evaluation for second tumors, and in selected circumstances testing for germline mutations such as for MEN1.[1]
Pathophysiology
NETs are believed to arise from various neuroendocrine cells whose normal function is to serve at the neuroendocrine interface. Neuroendocrine cells are present not only in endocrine glands throughout the body that produce hormones, but are found in all body tissues.[59]
Diagnosis
Markers
Symptoms from secreted hormones may prompt measurement of the corresponding hormones in the blood or their associated urinary products, for initial diagnosis or to assess the interval change in the tumor. Secretory activity of the tumor cells is sometimes dissimilar to the tissue immunoreactivity to particular hormones.[60]

Given the diverse secretory activity of NETs there are many other potential markers, but a limited panel is usually sufficient for clinical purposes.[1] Aside from the hormones of secretory tumors, the most important markers are:
- chromogranin A (CgA), present in 99% of metastatic carcinoid tumors[61]
- urine 5-hydroxyindoleacetic acid (5-HIAA)
- neuron-specific enolase (NSE, gamma-gamma dimer)
- synaptophysin (P38)
Newer markers include N-terminally truncated variant of Hsp70 is present in NETs but absent in normal pancreatic islets.[62] High levels of CDX2, a homeobox gene product essential for intestinal development and differentiation, are seen in intestinal NETs. Neuroendocrine secretory protein-55, a member of the chromogranin family, is seen in pancreatic endocrine tumors but not intestinal NETs.[62]
Imaging
For morphological imaging, CT-scans, MRIs, sonography (ultrasound), and endoscopy (including endoscopic ultrasound) are commonly used. Multiphase CT and MRI are typically used both for diagnostics and for evaluation of therapy. The multiphase CT should be performed before and after an intravenous injection of an iodine-based contrast agent, both in the late arterial phase and in the portal venous phase (triple-phase study). While MRI is generally superior to CT, both for detection of the primary tumor and for evaluation of metastases, CECT is more widely available, even at academic institutions. Therefore, multiphase CT is often the modality of choice.[5][63]
Advances in nuclear medicine imaging, also known as molecular imaging, have improved diagnostic and treatment paradigms in patients with neuroendocrine tumors. This is because of its ability to not only identify sites of disease but also characterize them. Neuroendocrine tumours express somatostatin receptors providing a unique target for imaging. Octreotide is a synthetic modification of somatostatin with a longer half-life. OctreoScan, also called somatostatin receptor scintigraphy (SRS or SSRS), utilizes intravenously administered octreotide that is chemically bound to a radioactive substance, often indium-111, to detect larger lesions with tumor cells that are avid for octreotide.
Somatostatin receptor imaging can now be performed with positron emission tomography (PET) which offers higher resolution, three-dimensional and more rapid imaging. Gallium-68 receptor PET-CT is much more accurate than an Octreotide scan.[64] Thus, octreotide scanning for NET tumors is being increasingly replaced by gallium-68 DOTATOC scan.[65]
Imaging with fluorine-18 fluorodeoxyglucose (FDG) PET may be valuable to image some neuroendocrine tumors.[66] This scan is performed by injected radioactive sugar intravenously. Tumors that grow more quickly use more sugar. Using this scan, the aggressiveness of the tumor can be assessed. However, neuroendocrine tumors are often slow growing and indolent, and these do not show well on FDG-PET.
Functional imaging with gallium-labelled somatostatin analog and 18F-FDG PET tracers ensures better staging and prognostication of neuroendocrine neoplasms.[67]
The combination of somatostatin receptor and FDG PET imaging is able to quantify somatostatin receptor cell surface (SSTR) expression and glycolytic metabolism, respectively.[66] The ability to perform this as a whole body study is highlighting the limitations of relying on histopathology obtained from a single site. This is enabling better selection of the most appropriate therapy for an individual patient.[68]
Histopathology


Features in common
Neuroendocrine tumors, despite differing embryological origin, have common phenotypic characteristics. NETs show tissue immunoreactivity for markers of neuroendocrine differentiation (pan-neuroendocrine tissue markers) and may secrete various peptides and hormones. There is a lengthy list of potential markers in neuroendocrine tumors; several reviews provide assistance in understanding these markers.[70][60] Widely used neuroendocrine tissue markers are various chromogranins, synaptophysin and PGP9.5. Neuron-specific enolase (NSE) is less specific.[1][8] The nuclear neuroendocrine marker insulinoma-associated protein-1 (INSM1) has proven to be sensitive as well as highly specific for neuroendocrine differentiation.[71]
NETs are often small, yellow or tan masses, often located in the submucosa or more deeply intramurally, and they can be very firm due to an accompanying intense desmoplastic reaction. The overlying mucosa may be either intact or ulcerated. Some GEP-NETs invade deeply to involve the mesentery.[72] Histologically, NETs are an example of "small blue cell tumors," showing uniform cells which have a round to oval stippled nucleus and scant, pink granular cytoplasm. The cells may align variously in islands, glands or sheets. High power examination shows bland cytopathology. Electron microscopy can identify secretory granules. There is usually minimal pleomorphism but less commonly there can be anaplasia, mitotic activity, and necrosis.
Some neuroendocrine tumor cells possess especially strong hormone receptors, such as somatostatin receptors and uptake hormones strongly. This avidity can assist in diagnosis and may make some tumors vulnerable to hormone targeted therapies.
Argentaffin and hormone secretion
NETs from a particular anatomical origin often show similar behavior as a group, such as the foregut (which conceptually includes pancreas, and even thymus, airway and lung NETs), midgut and hindgut; individual tumors within these sites can differ from these group benchmarks:
- Foregut NETs are argentaffin negative. Despite low serotonin content, they often secrete 5-hydroxytryptophan (5-HTP), histamine, and several polypeptide hormones. There may be associated atypical carcinoid syndrome, acromegaly, Cushing disease, other endocrine disorders, telangiectasia, or hypertrophy of the skin in the face and upper neck.[73] These tumors can metastasize to bone.
- Midgut NETs are argentaffin positive, can produce high levels of serotonin 5-hydroxytryptamine (5-HT), kinins, prostaglandins, substance P (SP), and other vasoactive peptides, and sometimes produce corticotropic hormone (previously adrenocorticotropic hormone [ACTH]). Bone metastasis is uncommon.
- Hindgut NETs are argentaffin negative and rarely secrete 5-HT, 5-HTP, or any other vasoactive peptides. Bone metastases are not uncommon.
Treatment
Several issues help define appropriate treatment of a neuroendocrine tumor, including its location, invasiveness, hormone secretion, and metastasis. Treatments may be aimed at curing the disease or at relieving symptoms (palliation). Observation may be feasible for non-functioning low-grade neuroendocrine tumors. If the tumor is locally advanced or has metastasized, but is nonetheless slowly growing, treatment that relieves symptoms may often be preferred over immediate challenging surgeries.
Intermediate and high grade tumors (noncarcinoids) are usually best treated by various early interventions (active therapy) rather than observation (wait-and-see approach).[74]
Treatments have improved over the past several decades, and outcomes are improving.[49] In malignant carcinoid tumors with carcinoid syndrome, the median survival has improved from two years to more than eight years.[75]
Detailed guidelines for managing neuroendocrine tumors are available from ESMO,[76] NCCN[77] and a UK panel.[1] The NCI has guidelines for several categories of NET: islet cell tumors of the pancreas,[78] gastrointestinal carcinoids,[79] Merkel cell tumors[80] and pheochromocytoma/paraganglioma.[81] However, effective predictive biomarkers are yet to be discovered. Similarly, recent advances in understanding neuroendocrine tumor's molecular and genomic alterations still have to find their ways into a definitive management strategy.[82]
Surgery
Even if the tumor has advanced and metastasized, making curative surgery infeasible, surgery often has a role in neuroendocrine cancers for palliation of symptoms and possibly increased lifespan.[74]
Cholecystectomy is recommended if there is a consideration of long-term treatment with somatostatin analogs.[83]: 46
Symptomatic relief
In secretory tumors, somatostatin analogs given subcutaneously or intramuscularly alleviate symptoms by blocking hormone release. A consensus review has reported on the use of somatostatin analogs for GEP-NETs.[84]
These medications may also anatomically stabilize or shrink tumors, as suggested by the PROMID study (Placebo-controlled prospective randomized study on the antiproliferative efficacy of Octreotide LAR in patients with metastatic neuroendocrine MIDgut tumors): at least in this subset of NETs, average tumor stabilization was 14.3 months compared to 6 months for placebo.[85]
The CLARINET study (a randomized, double-blind, placebo-controlled study on the antiproliferative effects of lanreotide in patients with enteropancreatic neuroendocrine tumors) further demonstrated the antiproliferative potential of lanreotide, a somatostatin analog and recently approved FDA treatment for GEP-NETS. In this study, lanreotide showed a statistically significant improvement in progression-free survival, meeting its primary endpoint. The disease in sixty-five percent of patients treated with lanreotide in the study had not progressed or caused death at 96 weeks, the same was true of 33% of patients on placebo. This represented a 53% reduction in risk of disease progression or death with lanreotide based on a hazard ratio of .47.[86]
Lanreotide is the first and only FDA approved antitumor therapy demonstrating a statistically significant progression-free survival benefit in a combined population of patients with GEP-NETS.
Other medications that block particular secretory effects can sometimes relieve symptoms.[52]
Chemotherapy
Interferon is sometimes used to treat GEP-NETs.[87] Its effectiveness is somewhat uncertain, but low doses can be titrated within each person, often considering the effect on the blood leukocyte count;[87] Interferon is often used in combination with other agents, especially somatostatin analogs such as octreotide.[88]
Gastrointestinal neuroendocrine tumors
Most gastrointestinal carcinoid tumors tend not to respond to chemotherapy agents,[52] showing 10 to 20% response rates that are typically less than 6 months. Combining chemotherapy medications has not usually been of significant improvement[52] showing 25 to 35% response rates that are typically less than 9 months.
The exceptions are poorly differentiated (high-grade or anaplastic) metastatic disease, where cisplatin with etoposide may be used[52] and Somatostatin Receptor Scintigraphy (SSRS) negative tumors which had a response rate in excess of 70% compared to 10% in strongly positive SRSS carcinoid tumors.[1]
PanNETs
Targeted therapy with everolimus (Afinitor) and sunitinib (Sutent) is approved by the FDA in unresectable, locally advanced or metastatic PanNETs. Some PanNETs are more responsive to chemotherapy than gastroenteric carcinoid tumors. Several agents have shown activity[52] and combining several medicines, particularly doxorubicin with streptozocin and fluorouracil (5-FU or f5U), is often more effective. Although marginally effective in well-differentiated PETs, cisplatin with etoposide is active in poorly differentiated neuroendocrine cancers (PDNECs).[52]
Radionuclide therapy
Peptide receptor radionuclide therapy (PRRT) is a type of radioisotope therapy (RIT)[9] in which a peptide or hormone conjugated to a radionuclide or radioligand is given intravenously, the peptide or neuroamine hormone previously having shown good uptake of a tracer dose, using Somatostatin receptor imaging as detailed above. This type of radiotherapy is a systemic therapy and will impact somatostatin positive disease.[89] The peptide receptor may be bound to lutetium-177, yttrium-90, indium-111 and other isotopes including alpha emitters.[90] This is a highly targeted and effective therapy with minimal side effects in tumors with high levels of somatostatin cell surface expression, because the radiation is absorbed at the sites of the tumor, or excreted in the urine. The radioactively labelled hormones enter the tumor cells which, together with nearby cells, are damaged by the attached radiation. Not all cells are immediately killed; cell death can go on for up to two years.
PRRT was initially used for low grade NETs. It is also very useful in more aggressive NETs such as Grade 2 and 3 NETs[91][92] provided they demonstrate high uptake on SSTR imaging to suggest benefit.
Hepatic artery
Metastases to the liver can be treated by several types of hepatic artery treatments based on the observation that tumor cells get nearly all their nutrients from the hepatic artery, while the normal cells of the liver get about 70–80 percent of their nutrients and 50% their oxygen supply from the portal vein, and thus can survive with the hepatic artery effectively blocked.[49][93]
- Hepatic artery embolization (HAE) occludes the blood flow to the tumors, achieving significant tumor shrinkage in over 80%.[51] In hepatic artery chemotherapy, the chemotherapy agents are given into the hepatic artery, often by steady infusion over hours or even days. Compared with systemic chemotherapy, a higher proportion of the chemotherapy agents are (in theory) delivered to the lesions in the liver.[93]
- Hepatic artery chemoembolization (HACE), sometimes called transarterial chemoembolization (TACE), combines hepatic artery embolization with hepatic artery chemoinfusion: embospheres bound with chemotherapy agents, injected into the hepatic artery, lodge in downstream capillaries. The spheres not only block blood flow to the lesions, but by halting the chemotherapy agents in the neighborhood of the lesions, they provide much better targeting leverage than chemoinfusion provides.
- Selective internal radiation therapy (SIRT)[94] for neuroendocrine metastases to the liver[95] delivers radioactive microsphere therapy (RMT) by injection into the hepatic artery, lodging (as with HAE and HACE) in downstream capillaries. In contrast to hormone-delivered radiotherapy, the lesions need not overexpress peptide receptors. The mechanical targeting delivers the radiation from the yttrium-labeled microspheres selectively to the tumors without unduly affecting the normal liver.[96] This type of treatment is FDA approved for liver metastases secondary to colorectal carcinoma and is under investigation for treatment of other liver malignancies, including neuroendocrine malignancies.[94]
Other therapies
AdVince, a type of gene therapy using a genetically modified oncolytic adenovirus[97] and supported by the crowdfunding campaign iCancer[98] was used in a Phase 1 trial against NET in 2016.[99]
Further efforts towards more personalized therapies in neuroendocrine tumors are undertaken [100] i.a. combining drug screening platforms and patient-derived ex vivo cell cultures that mimic relevant aspects of the original tumors.[101][102]
Epidemiology
Although estimates vary, the annual incidence of clinically significant neuroendocrine tumors is approximately 2.5–5 per 100,000;[103] two thirds are carcinoid tumors and one third are other NETs.
The prevalence has been estimated as 35 per 100,000,[103] and may be considerably higher if clinically silent tumors are included. An autopsy study of the pancreas in people who died from unrelated causes discovered a remarkably high incidence of tiny asymptomatic NETs. Routine microscopic study of three random sections of the pancreas found NETs in 1.6%, and multiple sections identified NETs in 10%.[104] As diagnostic imaging increases in sensitivity, such as endoscopic ultrasonography, very small, clinically insignificant NETs may be coincidentally discovered; being unrelated to symptoms, such neoplasms may not require surgical excision.
History
Small intestinal neuroendocrine tumors were first distinguished from other tumors in 1907.[105][48] They were named carcinoid tumors because their slow growth was considered to be "cancer-like" rather than truly cancerous.[48]
However, in 1938 it was recognized that some of these small bowel tumors could be malignant.[105][48] Despite the differences between these two original categories, and further complexities due to subsequent inclusion of other NETs of pancreas and pulmonary origin, all NETs are sometimes (incorrectly) subsumed into the term "carcinoid".
Enterochromaffin cells, which give rise to carcinoid tumors, were identified in 1897 by Nikolai Kulchitsky and their secretion of serotonin was established in 1953[105] when the "flushing" effect of serotonin had become clinically recognized. Carcinoid heart disease was identified in 1952, and carcinoid fibrosis in 1961.[105]
Neuroendocrine tumors were sometimes called APUDomas because these cells often show amine precursor (L-DOPA and 5-hydroxytryptophan) uptake and decarboxylation to produce biogenic amines such as catecholamines and serotonin. Although this behavior was also part of the disproven hypothesis that these cells might all embryologically arise from the neural crest,[59][74][75] neuroendocrine cells sometimes produce various types of hormones and amines,[75] and they can also have strong receptors for other hormones to which they respond.
There have been multiple nomenclature systems for these tumors,[4] and the differences between these schema have often been confusing. Nonetheless, these systems all distinguish between well-differentiated (low and intermediate-grade) and poorly differentiated (high-grade) NETs. Cellular proliferative rate is of considerable significance in this prognostic assessment.[4]
References
- 1 2 3 4 5 6 7 8 9 10 11 12 13 Ramage JK, Davies AH, Ardill J, Bax N, Caplin M, Grossman A, et al. (June 2005). "Guidelines for the management of gastroenteropancreatic neuroendocrine (including carcinoid) tumours". Gut. 54. 54 (Suppl 4): iv1 – i16. doi:10.1136/gut.2004.053314. PMC 1867801. PMID 15888809.
- ↑ Scalettar BA, Jacobs C, Fulwiler A, Prahl L, Simon A, Hilken L, Lochner JE (September 2012). "Hindered submicron mobility and long-term storage of presynaptic dense-core granules revealed by single-particle tracking". Developmental Neurobiology. 72 (9): 1181–1195. doi:10.1002/dneu.20984. PMC 3512567. PMID 21976424.
- ↑ Oronsky B, Ma PC, Morgensztern D, Carter CA (December 2017). "Nothing But NET: A Review of Neuroendocrine Tumors and Carcinomas". Neoplasia. 19 (12): 991–1002. doi:10.1016/j.neo.2017.09.002. PMC 5678742. PMID 29091800.
- 1 2 3 4 5 6 Klimstra DS, Modlin IR, Coppola D, Lloyd RV, Suster S (August 2010). "The pathologic classification of neuroendocrine tumors: a review of nomenclature, grading, and staging systems". Pancreas. 39 (6): 707–712. doi:10.1097/MPA.0b013e3181ec124e. PMID 20664470. S2CID 3735444.
- 1 2 3 Tan EH, Tan CH (January 2011). "Imaging of gastroenteropancreatic neuroendocrine tumors". World Journal of Clinical Oncology. 2 (1): 28–43. doi:10.5306/wjco.v2.i1.28. PMC 3095463. PMID 21603312.
- ↑ van Eeden S, Offerhaus GJ, Hart AA, Boerrigter L, Nederlof PM, Porter E, van Velthuysen ML (December 2007). "Goblet cell carcinoid of the appendix: a specific type of carcinoma". Histopathology. 51 (6): 763–773. doi:10.1111/j.1365-2559.2007.02883.x. PMID 18042066. S2CID 20185589.
- 1 2 3 4 Rindi G, Mete O, Uccella S, Basturk O, La Rosa S, Brosens LA, et al. (March 2022). "Overview of the 2022 WHO Classification of Neuroendocrine Neoplasms". Endocrine Pathology. 33 (1): 115–154. doi:10.1007/s12022-022-09708-2. PMID 35294740. S2CID 247455289.
- 1 2 Liu Y, Sturgis CD, Grzybicki DM, Jasnosz KM, Olson PR, Tong M, et al. (September 2001). "Microtubule-associated protein-2: a new sensitive and specific marker for pulmonary carcinoid tumor and small cell carcinoma". Modern Pathology. 14 (9): 880–885. doi:10.1038/modpathol.3880406. PMID 11557784. S2CID 24740130.
- 1 2 Rufini V, Calcagni ML, Baum RP (July 2006). "Imaging of neuroendocrine tumors". Seminars in Nuclear Medicine. 36 (3): 228–247. doi:10.1053/j.semnuclmed.2006.03.007. PMID 16762613.
- ↑ Soga J (December 2003). "Carcinoids and their variant endocrinomas. An analysis of 11842 reported cases". Journal of Experimental & Clinical Cancer Research. 22 (4): 517–530. PMID 15053292.
- ↑ Soga J, Yakuwa Y, Osaka M (October 1999). "Evaluation of 342 cases of mediastinal/thymic carcinoids collected from literature: a comparative study between typical carcinoids and atypical varieties". Annals of Thoracic and Cardiovascular Surgery. 5 (5): 285–292. PMID 10550713.
- 1 2 Oberg K, Jelic S (May 2008). "Neuroendocrine bronchial and thymic tumors: ESMO clinical recommendation for diagnosis, treatment and follow-up". Annals of Oncology. 19 (Suppl 2): ii102 – ii103. doi:10.1093/annonc/mdn116. PMID 18456740.
- ↑ Beasley MB, Brambilla E, Travis WD (April 2005). "The 2004 World Health Organization classification of lung tumors". Seminars in Roentgenology. 40 (2): 90–97. doi:10.1053/j.ro.2005.01.001. PMID 15898407.
- ↑ Gustafsson BI, Kidd M, Chan A, Malfertheiner MV, Modlin IM (July 2008). "Bronchopulmonary neuroendocrine tumors". Cancer. 113 (1): 5–21. doi:10.1002/cncr.23542. PMID 18473355. S2CID 22143641.
- ↑ Wick MR, Berg LC, Hertz MI (June 1992). "Large cell carcinoma of the lung with neuroendocrine differentiation. A comparison with large cell "undifferentiated" pulmonary tumors". American Journal of Clinical Pathology. 97 (6): 796–805. doi:10.1093/ajcp/97.6.796. PMID 1317668.
- ↑ Massironi S, Sciola V, Peracchi M, Ciafardini C, Spampatti MP, Conte D (September 2008). "Neuroendocrine tumors of the gastro-entero-pancreatic system". World Journal of Gastroenterology. 14 (35): 5377–5384. doi:10.3748/wjg.14.5377. PMC 2744160. PMID 18803349.
- ↑ Modlin IM, Oberg K, Chung DC, Jensen RT, de Herder WW, Thakker RV, et al. (January 2008). "Gastroenteropancreatic neuroendocrine tumours". The Lancet. Oncology. 9 (1): 61–72. doi:10.1016/S1470-2045(07)70410-2. PMID 18177818. S2CID 46127116.
- ↑ Metz DC, Jensen RT (November 2008). "Gastrointestinal neuroendocrine tumors: pancreatic endocrine tumors". Gastroenterology. 135 (5): 1469–1492. doi:10.1053/j.gastro.2008.05.047. PMC 2612755. PMID 18703061.
- ↑ Griniatsos J, Michail O (April 2010). "Appendiceal neuroendocrine tumors: Recent insights and clinical implications". World Journal of Gastrointestinal Oncology. 2 (4): 192–196. doi:10.4251/wjgo.v2.i4.192. PMC 2999180. PMID 21160597.
- ↑ Ni SJ, Sheng WQ, Du X (April 2010). "Pathologic research update of colorectal neuroendocrine tumors". World Journal of Gastroenterology. 16 (14): 1713–1719. doi:10.3748/wjg.v16.i14.1713. PMC 2852818. PMID 20380002.
- ↑ Konishi T, Watanabe T, Nagawa H, Oya M, Ueno M, Kuroyanagi H, et al. (May 2010). "Treatment of colorectal carcinoids: A new paradigm". World Journal of Gastrointestinal Surgery. 2 (5): 153–156. doi:10.4240/wjgs.v2.i5.153. PMC 2999232. PMID 21160865.
- ↑ Soga J (December 2002). "Primary hepatic endocrinomas (carcinoids and variant neoplasms). A statistical evaluation of 126 reported cases". Journal of Experimental & Clinical Cancer Research. 21 (4): 457–468. PMID 12636090.
- ↑ Nikfarjam M, Muralidharan V, Christophi C (2004). "Primary hepatic carcinoid tumours". HPB. 6 (1): 13–17. doi:10.1080/13651820310017228. PMC 2020649. PMID 18333038.
- ↑ Moriura S, Ikeda S, Hirai M, Naiki K, Fujioka T, Yokochi K, Gotou S (September 1993). "Hepatic gastrinoma". Cancer. 72 (5): 1547–1550. doi:10.1002/1097-0142(19930901)72:5<1547::AID-CNCR2820720510>3.0.CO;2-C. PMID 8348490.
- ↑ Soga J (March 2003). "Primary endocrinomas (carcinoids and variant neoplasms) of the gallbladder. A statistical evaluation of 138 reported cases". Journal of Experimental & Clinical Cancer Research. 22 (1): 5–15. PMID 12725316.
- ↑ Soga J, Osaka M, Yakuwa Y (2001). "Gut-endocrinomas (carcinoids and related endocrine variants) of the breast: an analysis of 310 reported cases". International Surgery. 86 (1): 26–32. PMID 11890336.
- ↑ Murali R, Kneale K, Lalak N, Delprado W (November 2006). "Carcinoid tumors of the urinary tract and prostate". Archives of Pathology & Laboratory Medicine. 130 (11): 1693–1706. doi:10.5858/2006-130-1693-CTOTUT. PMID 17076534.
- ↑ Mikuz G (1993). "[Non-urothelial tumors of the urinary tract]". Verhandlungen der Deutschen Gesellschaft für Pathologie. 77: 180–198. PMID 7511278.
- ↑ Soga J, Osaka M, Yakuwa Y (September 2001). "Gut-endocrinomas (carcinoids and related endocrine variants) of the uterine cervix: an analysis of 205 reported cases". Journal of Experimental & Clinical Cancer Research. 20 (3): 327–334. PMID 11718210.
- ↑ Usmani S, Orevi M, Stefanelli A, Zaniboni A, Gofrit ON, Bnà C, et al. (June 2019). "Neuroendocrine differentiation in castration resistant prostate cancer. Nuclear medicine radiopharmaceuticals and imaging techniques: A narrative review". Critical Reviews in Oncology/Hematology. 138: 29–37. doi:10.1016/j.critrevonc.2019.03.005. PMID 31092382. S2CID 131934021.
- ↑ Davies AH, Beltran H, Zoubeidi A (May 2018). "Cellular plasticity and the neuroendocrine phenotype in prostate cancer". Nature Reviews. Urology. 15 (5): 271–286. doi:10.1038/nrurol.2018.22. PMID 29460922. S2CID 4732323.
- 1 2 3 4 5 Jensen RT, Berna MJ, Bingham DB, Norton JA (October 2008). "Inherited pancreatic endocrine tumor syndromes: advances in molecular pathogenesis, diagnosis, management, and controversies". Cancer. 113 (7 Suppl): 1807–1843. doi:10.1002/cncr.23648. PMC 2574000. PMID 18798544.
- 1 2 Hirsch NP, Murphy A, Radcliffe JJ (April 2001). "Neurofibromatosis: clinical presentations and anaesthetic implications". British Journal of Anaesthesia. 86 (4): 555–564. doi:10.1093/bja/86.4.555. PMID 11573632.
- 1 2 3 Lodish MB, Stratakis CA (June 2010). "Endocrine tumours in neurofibromatosis type 1, tuberous sclerosis and related syndromes". Best Practice & Research. Clinical Endocrinology & Metabolism. 24 (3): 439–449. doi:10.1016/j.beem.2010.02.002. PMC 2939061. PMID 20833335.
- 1 2 Dworakowska D, Grossman AB (March 2009). "Are neuroendocrine tumours a feature of tuberous sclerosis? A systematic review". Endocrine-Related Cancer. 16 (1): 45–58. doi:10.1677/ERC-08-0142. PMID 18978035.
- 1 2 "Carney Complex, type 1; CNC1". OMIM - Online Mendelian Inheritance in Man. OMIM 160980.
- 1 2 "Carney Complex, type 2; CNC2". OMIM - Online Mendelian Inheritance in Man. OMIM 605244.
- ↑ Bosman FT, Carneiro F, Hruban RH, Theise ND, eds. (2010). WHO Classification of Tumours of the Digestive System (4 ed.). Lyon: International Agency for Research on Cancer. pp. 13–14. ISBN 978-92-832-2432-7.
- ↑ Basturk O, Yang Z, Tang LH, Hruban RH, Adsay V, McCall CM, et al. (May 2015). "The high-grade (WHO G3) pancreatic neuroendocrine tumor category is morphologically and biologically heterogenous and includes both well differentiated and poorly differentiated neoplasms". The American Journal of Surgical Pathology. 39 (5): 683–690. doi:10.1097/PAS.0000000000000408. PMC 4398606. PMID 25723112.
- ↑ Amin MB, ed. (2017). AJCC Cancer Staging Manual (8 ed.). Springer. p. 351. ISBN 978-3-319-40617-6.
- ↑ Amin MB, ed. (2017). "29 – Neuroendocrine Tumors of the Stomach". AJCC Cancer Staging Manual (8 ed.). Springer. p. 355. ISBN 978-3-319-40617-6.
- ↑ Amin MB (2017). "30 – Neuroendocrine Tumors of the Duodenum & Ampulla of Vater". AJCC Cancer Staging Manual (8 ed.). Springer. p. 369. ISBN 978-3-319-40617-6.
- ↑ AJCC, 8th edition: Klimstra DS, Yang Z (29 October 2019). "Pathology, classification, and grading of neuroendocrine neoplasms arising in the digestive system". UpToDate.
- ↑ Amin MB (2017). "32 – Neuroendocrine Tumors of the Appendix". AJCC Cancer Staging Manual (8 ed.). Springer. p. 392. ISBN 978-3-319-40617-6.
- ↑ Amin MB (2017). "33 – Neuroendocrine Tumors of the Colon and Rectum". AJCC Cancer Staging Manual (8 ed.). Springer. p. 399. ISBN 978-3-319-40617-6.
- ↑ Amin MB (2017). "30 – Neuroendocrine Tumors of the Pancreas". AJCC Cancer Staging Manual (8 ed.). Springer. pp. 415–16. ISBN 978-3-319-40617-6.
- ↑ Kimura W, Kuroda A, Morioka Y (July 1991). "Clinical pathology of endocrine tumors of the pancreas. Analysis of autopsy cases". Digestive Diseases and Sciences. 36 (7): 933–942. doi:10.1007/BF01297144. PMID 2070707. S2CID 20567425. "[In] 800 autopsy cases, ... incidence of tumor was 10% (6/60) in individuals having histiological studies of all sections of the pancreas"
- 1 2 3 4 Arnold R, Göke R, Wied M, Behr T (2003). "Chapter 15 Neuroendocrine Gastro-Entero-Pancreatic (GEP) Tumors". In Scheppach W, Bresalier RS, Tytgat GN (eds.). Gastrointestinal and Liver Tumors. Berlin: Springer. pp. 195–233. ISBN 978-3-540-43462-7.
- 1 2 3 4 Pommier R (October 2003). The role of surgery and chemoembolization in the management of carcinoid. California Carcinoid Fighters Conference. Archived from the original on 2015-09-15.
- ↑ "Carcinoid Tumor Overview". Health Communities. Archived from the original on 2012-03-03.
- 1 2 3 4 5 6 7 8 Kvols LK (2002). "Carcinoid Tumors and the Carcinoid Syndrome: What's New in the Therapeutic Pipeline". Carcinoid Symposium 2002. The Carcinoid Cancer Foundation. Archived from the original on 2015-01-05.
- 1 2 3 4 5 6 7 Benson AB, Myerson RJ, Sasson AR (March 2011). "Pancreatic, neuroendocrine GI, and adrenal cancers.". Cancer Management: A Multidisciplinary Approach (13th ed.). UBM Medica. ISBN 978-0-615-41824-7. Archived from the original on 2011-05-15., cancernetwork.com; accessed November 8, 2015.
- ↑ "Cushing's Syndrome". The Lecturio Medical Concept Library. Retrieved 28 September 2021.
- 1 2 PDQ Adult Treatment Editorial Board (August 2022). "Pancreatic Neuroendocrine Tumors (Islet Cell Tumors) Treatment (PDQ®): Health Professional Version". PDQ Cancer Information Summaries [Internet]. Bethesda (MD): National Cancer Institute. PMID 26389309.
- ↑ Burns WR, Edil BH (March 2012). "Neuroendocrine pancreatic tumors: guidelines for management and update". Current Treatment Options in Oncology. 13 (1): 24–34. doi:10.1007/s11864-011-0172-2. PMID 22198808. S2CID 7329783.
- ↑ Bostanci A (February 2005). "Wildlife biology. A devil of a disease". Science. 307 (5712): 1035. doi:10.1126/science.307.5712.1035. PMID 15718445. S2CID 54100368.
The tumors [of Devil facial tumor disease] have been characterized as a neuroendocrine cancer
- ↑ Kinver M (January 1, 2010). "Tasmanian devil facial cancer origins 'identified'". BBC. Archived from the original on January 2, 2010.
- ↑ Walsh B (January 1, 2010). "Decoding the Tasmanian Devil's Deadly Cancer". Time. Archived from the original on January 8, 2010.
- 1 2 Langley K (September 1994). "The neuroendocrine concept today". Annals of the New York Academy of Sciences. 733 (1): 1–17. Bibcode:1994NYASA.733....1L. doi:10.1111/j.1749-6632.1994.tb17251.x. PMID 7978856. S2CID 33139633.
- 1 2 Ferolla P, Faggiano A, Mansueto G, Avenia N, Cantelmi MG, Giovenali P, et al. (March 2008). "The biological characterization of neuroendocrine tumors: the role of neuroendocrine markers". Journal of Endocrinological Investigation. 31 (3): 277–286. doi:10.1007/bf03345602. PMID 18401212. S2CID 25108086.
- ↑ McMorran J, Crowther DC, McMorran S, Prince C, YoungMin S, Pleat J, Wacogne I. "investigations – General Practice Notebook". www.gpnotebook.co.uk. Archived from the original on 24 February 2017. Retrieved 23 February 2017.
- 1 2 Oberg K (July 2005). "Neuroendocrine tumors of the gastrointestinal tract: recent advances in molecular genetics, diagnosis, and treatment". Current Opinion in Oncology. 17 (4): 386–391. doi:10.1097/01.cco.0000167739.56948.a9. PMID 15933475. S2CID 208286399.
- ↑ van Essen M, Sundin A, Krenning EP, Kwekkeboom DJ (February 2014). "Neuroendocrine tumours: the role of imaging for diagnosis and therapy". Nature Reviews. Endocrinology. 10 (2): 102–114. doi:10.1038/nrendo.2013.246. PMID 24322649. S2CID 40129404.
- ↑ Hofman MS, Kong G, Neels OC, Eu P, Hong E, Hicks RJ (February 2012). "High management impact of Ga-68 DOTATATE (GaTate) PET/CT for imaging neuroendocrine and other somatostatin expressing tumours". Journal of Medical Imaging and Radiation Oncology. 56 (1): 40–47. doi:10.1111/j.1754-9485.2011.02327.x. PMID 22339744. S2CID 21843609.
- ↑ Scott AT, Howe JR (August 2018). "Management of Small Bowel Neuroendocrine Tumors". Journal of Oncology Practice. 14 (8): 471–482. doi:10.1200/JOP.18.00135. PMC 6091496. PMID 30096273.
- 1 2 Hofman MS, Hicks RJ (July 2012). "Changing paradigms with molecular imaging of neuroendocrine tumors". Discovery Medicine. 14 (74): 71–81. PMID 22846204. Retrieved November 8, 2015.
- ↑ Hofland J, Kaltsas G, de Herder WW (April 2020). "Advances in the Diagnosis and Management of Well-Differentiated Neuroendocrine Neoplasms". Endocrine Reviews. 41 (2): 371–403. doi:10.1210/endrev/bnz004. PMC 7080342. PMID 31555796.
- ↑ Nilica B, Waitz D, Stevanovic V, Uprimny C, Kendler D, Buxbaum S, et al. (August 2016). "Direct comparison of (68)Ga-DOTA-TOC and (18)F-FDG PET/CT in the follow-up of patients with neuroendocrine tumour treated with the first full peptide receptor radionuclide therapy cycle". European Journal of Nuclear Medicine and Molecular Imaging. 43 (9): 1585–1592. doi:10.1007/s00259-016-3328-2. PMC 4932132. PMID 26922350.
- ↑ Van Buren G, Rashid A, Yang AD, Abdalla EK, Gray MJ, Liu W, et al. (August 2007). "The development and characterization of a human midgut carcinoid cell line". Clinical Cancer Research. 13 (16): 4704–4712. doi:10.1158/1078-0432.CCR-06-2723. PMID 17699847.
- ↑ Berretta M, Cappellani A, Di Vita M, Berretta S, Nasti G, Bearz A, et al. (January 2010). "Biomarkers in neuroendocrine tumors". Frontiers in Bioscience. 2 (1): 332–342. doi:10.2741/s68. PMID 20036951.
- ↑ Mukhopadhyay S, Dermawan JK, Lanigan CP, Farver CF (January 2019). "Insulinoma-associated protein 1 (INSM1) is a sensitive and highly specific marker of neuroendocrine differentiation in primary lung neoplasms: an immunohistochemical study of 345 cases, including 292 whole-tissue sections". Modern Pathology. 32 (1): 100–109. doi:10.1038/s41379-018-0122-7. PMID 30154579. S2CID 52110673.
- ↑ "Definition of Mesentery". MedicineNet. Retrieved 2018-04-21.
- ↑ Tebbi CK, Windle ML, Cripe TP, Sakamoto KM (1 April 2014). Coppes MJ (ed.). "Carcinoid Tumor". Medscape.com. WebMD LLC. Archived from the original on 15 December 2014. Retrieved 3 September 2014.
- 1 2 3 Warner RR (May 2005). "Enteroendocrine tumors other than carcinoid: a review of clinically significant advances". Gastroenterology. 128 (6): 1668–1684. doi:10.1053/j.gastro.2005.03.078. PMID 15887158.
- 1 2 3 Öberg K (1998). "Carcinoid Tumors: Current Concepts in Diagnosis and Treatment". The Oncologist. 3 (5): 339–345. doi:10.1634/theoncologist.3-5-339. PMID 10388123.
- ↑ Oberg K, Akerström G, Rindi G, Jelic S (May 2010). "Neuroendocrine gastroenteropancreatic tumours: ESMO Clinical Practice Guidelines for diagnosis, treatment and follow-up". Annals of Oncology. 21 (Suppl 5): v223 – v227. doi:10.1093/annonc/mdq192. PMID 20555086.
- ↑ Clark OH, Benson AB, Berlin JD, Choti MA, Doherty GM, Engstrom PF, et al. (July 2009). "NCCN Clinical Practice Guidelines in Oncology: neuroendocrine tumors". Journal of the National Comprehensive Cancer Network. 7 (7): 712–747. doi:10.6004/jnccn.2009.0050. PMID 19635226.
- ↑ "Islet Cell Tumors (Endocrine Pancreas)". National Cancer Institute. Archived from the original on 2011-06-07.
- ↑ "Gastrointestinal Carcinoid Tumors Treatment". National Cancer Institute. Archived from the original on 2011-06-27.
- ↑ "Merkel cell tumors". National Cancer Institute. 21 February 2006. Archived from the original on 2011-06-07.
- ↑ "Pheochromocytoma and Paraganglioma". National Cancer Institute. Archived from the original on 2011-06-07.
- ↑ Rinke A, Auernhammer CJ, Bodei L, Kidd M, Krug S, Lawlor R, et al. (September 2021). "Treatment of advanced gastroenteropancreatic neuroendocrine neoplasia, are we on the way to personalised medicine?". Gut. 70 (9): 1768–1781. doi:10.1136/gutjnl-2020-321300. PMID 33692095. S2CID 232172557.
- ↑ "Neuroendocrine tumors, NCCN Guidelines Version 1.2015" (PDF). NCCN Guidelines. National Comprehensive Cancer Network, Inc. November 11, 2014. Retrieved December 25, 2014.
- ↑ Oberg K, Kvols L, Caplin M, Delle Fave G, de Herder W, Rindi G, et al. (June 2004). "Consensus report on the use of somatostatin analogs for the management of neuroendocrine tumors of the gastroenteropancreatic system". Annals of Oncology. 15 (6): 966–973. doi:10.1093/annonc/mdh216. PMID 15151956.
- ↑ Rinke A, Müller HH, Schade-Brittinger C, Klose KJ, Barth P, Wied M, et al. (October 2009). "Placebo-controlled, double-blind, prospective, randomized study on the effect of octreotide LAR in the control of tumor growth in patients with metastatic neuroendocrine midgut tumors: a report from the PROMID Study Group". Journal of Clinical Oncology. 27 (28): 4656–4663. doi:10.1200/JCO.2009.22.8510. PMID 19704057.
- ↑ Caplin ME, Pavel M, Ćwikła JB, Phan AT, Raderer M, Sedláčková E, et al. (July 2014). "Lanreotide in metastatic enteropancreatic neuroendocrine tumors". The New England Journal of Medicine. 371 (3): 224–233. doi:10.1056/NEJMoa1316158. PMID 25014687.
- 1 2 Öberg K. Neuroendocrine Gastroenteropancreatic Tumours: Current Views on Diagnosis and Treatment. Business Briefing. European Oncology Review 2005; pp. 1–6.
- ↑ Chan JA, Kulke MH (May 2009). "Progress in the treatment of neuroendocrine tumors". Current Oncology Reports. 11 (3): 193–199. doi:10.1007/s11912-009-0028-0. PMC 4029419. PMID 19336011.
- ↑ Strosberg J, El-Haddad G, Wolin E, Hendifar A, Yao J, Chasen B, et al. (January 2017). "Phase 3 Trial of 177Lu-Dotatate for Midgut Neuroendocrine Tumors". The New England Journal of Medicine. 376 (2): 125–135. doi:10.1056/nejmoa1607427. hdl:2445/125256. PMC 5895095. PMID 28076709.
- ↑ Kratochwil C, Giesel FL, Bruchertseifer F, Mier W, Apostolidis C, Boll R, et al. (November 2014). "²¹³Bi-DOTATOC receptor-targeted alpha-radionuclide therapy induces remission in neuroendocrine tumours refractory to beta radiation: a first-in-human experience". European Journal of Nuclear Medicine and Molecular Imaging. 41 (11): 2106–2119. doi:10.1007/s00259-014-2857-9. PMC 4525192. PMID 25070685.
- ↑ Kashyap R, Hofman MS, Michael M, Kong G, Akhurst T, Eu P, et al. (February 2015). "Favourable outcomes of (177)Lu-octreotate peptide receptor chemoradionuclide therapy in patients with FDG-avid neuroendocrine tumours". European Journal of Nuclear Medicine and Molecular Imaging. 42 (2): 176–185. doi:10.1007/s00259-014-2906-4. PMID 25209134. S2CID 20740102.
- ↑ Hofman MS, Michael M, Kashyap R, Hicks RJ (June 2015). "Modifying the Poor Prognosis Associated with 18F-FDG-Avid NET with Peptide Receptor Chemo-Radionuclide Therapy (PRCRT)". Journal of Nuclear Medicine. 56 (6): 968–969. doi:10.2967/jnumed.115.154500. PMID 25814516. S2CID 207407820.
- 1 2 Fong T, Schoenfield LJ. "Arterial Chemotherapy Infusion of the Liver (and) Chemoembolization of the Liver (TACE)". medicinenet.com. Archived from the original on 2014-12-24. Retrieved 8 November 2015.
- 1 2 Welsh JS, Kennedy AS, Thomadsen B (2006). "Selective Internal Radiation Therapy (SIRT) for liver metastases secondary to colorectal adenocarcinoma". International Journal of Radiation Oncology, Biology, Physics. 66 (2 Suppl): S62 – S73. doi:10.1016/j.ijrobp.2005.09.011. PMID 16979443.
- ↑ Van De Wiele C, Defreyne L, Peeters M, Lambert B (June 2009). "Yttrium-90 labelled resin microspheres for treatment of primary and secondary malignant liver tumors". The Quarterly Journal of Nuclear Medicine and Molecular Imaging. 53 (3): 317–324. PMID 19521311.
- ↑ Salem R, Thurston KG, Carr BI, Goin JE, Geschwind JF (September 2002). "Yttrium-90 microspheres: radiation therapy for unresectable liver cancer". Journal of Vascular and Interventional Radiology. 13 (9 Pt 2): S223 – S229. doi:10.1016/S1051-0443(07)61790-4. PMID 12354840.
- ↑ Masters A (2014-10-14). "A plutocratic proposal". Mosaic. The Wellcome Trust. Archived from the original on 2016-05-29. Retrieved 2016-07-03.
- ↑ "iCancer web site". icancer.org.uk. Archived from the original on 2016-07-14. Retrieved 2016-07-03.
- ↑ Masters A (2016-07-02). "Can crowdfunding really cure cancer? Alexander Masters investigates a pioneering new project". The Telegraph. Archived from the original on 2016-07-03. Retrieved 2016-07-03.
- ↑ Detjen K, Hammerich L, Özdirik B, Demir M, Wiedenmann B, Tacke F, et al. (2020-07-02). "Models of Gastroenteropancreatic Neuroendocrine Neoplasms: Current Status and Future Directions". Neuroendocrinology. 111 (3): 217–236. doi:10.1159/000509864. PMID 32615560.
- ↑ April-Monn SL, Kirchner P, Detjen K, Bräutigam K, Trippel MA, Grob T, et al. (March 2024). "Patient derived tumoroids of high grade neuroendocrine neoplasms for more personalized therapies". npj Precision Oncology. 8 (1): 59. doi:10.1038/s41698-024-00549-2. PMC 10907580. PMID 38429350.
- ↑ April-Monn SL, Wiedmer T, Skowronska M, Maire R, Schiavo Lena M, Trippel M, et al. (2020-04-03). "Three-Dimensional Primary Cell Culture: A Novel Preclinical Model for Pancreatic Neuroendocrine Tumors". Neuroendocrinology. 111 (3): 273–287. doi:10.1159/000507669. hdl:11392/2447420. PMID 32241015. S2CID 214768622.
- 1 2 Oberg K, Castellano D (March 2011). "Current knowledge on diagnosis and staging of neuroendocrine tumors". Cancer and Metastasis Reviews. 30 (Suppl 1): 3–7. doi:10.1007/s10555-011-9292-1. PMID 21311954. S2CID 29720754.
- ↑ Kimura W, Kuroda A, Morioka Y (July 1991). "Clinical pathology of endocrine tumors of the pancreas. Analysis of autopsy cases". Digestive Diseases and Sciences. 36 (7): 933–942. doi:10.1007/BF01297144. PMID 2070707. S2CID 20567425.
- 1 2 3 4 Modlin IM, Shapiro MD, Kidd M (December 2004). "Siegfried Oberndorfer: origins and perspectives of carcinoid tumors". Human Pathology. 35 (12): 1440–1451. doi:10.1016/j.humpath.2004.09.018. PMID 15619202.